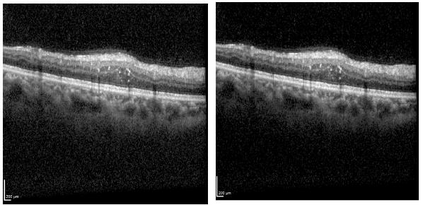

Ophthalmic diseases represent a significant global health issue, necessitating the use of advanced precise diagnostic tools. Optical Coherence Tomography (OCT) imagery which offers high-resolution cross-sectional images of the retina has become a pivotal imaging modality in ophthalmology. Traditionally physicians have manually detected various diseases and biomarkers from such diagnostic imagery. In recent times, deep learning techniques have been extensively used for medical diagnostic tasks enabling fast and precise diagnosis. This paper presents a novel approach for ophthalmic biomarker detection using an ensemble of Convolutional Neural Network (CNN) and Vision Transformer. While CNNs are good for feature extraction within the local context of the image, transformers are known for their ability to extract features from the global context of the image. Using an ensemble of both techniques allows us to harness the best of both worlds. Our method has been implemented on the OLIVES dataset to detect 6 major biomarkers from the OCT images and shows significant improvement of the macro averaged F1 score on the dataset.
翻译:暂无翻译